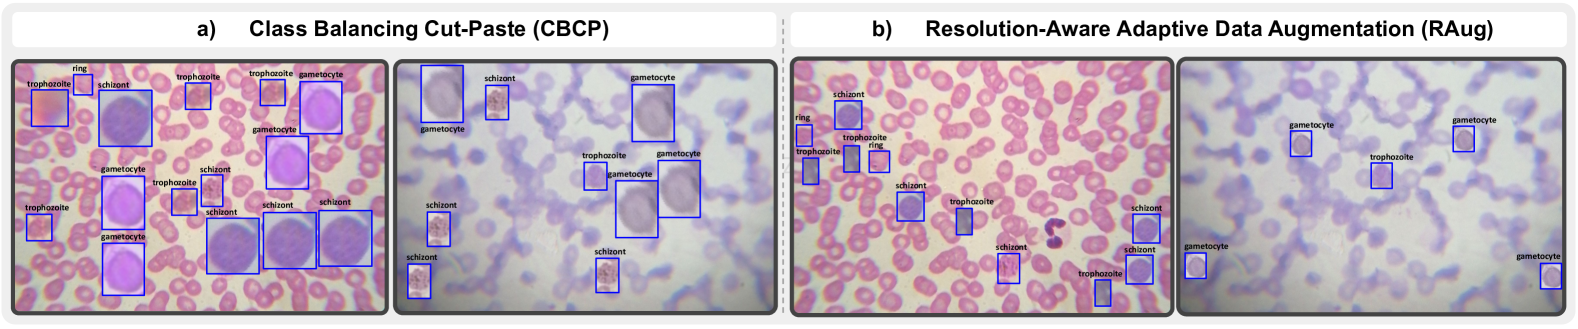
Refer to caption

MIAdapt: Source-free Few-shot Domain Adaptive Object Detection for Microscopic Images
Abstract
Existing generic unsupervised domain adaptation approaches require access to both a large labeled source dataset and a sufficient unlabeled target dataset during adaptation. However, collecting a large dataset, even if unlabeled, is a challenging and expensive endeavor, especially in medical imaging. In addition, constraints such as privacy issues can result in cases where source data is unavailable. Taking in consideration these challenges, we propose MIAdapt, an adaptive approach for Microscopic Imagery Adaptation as a solution for Source-free Few-shot Domain Adaptive Object detection (SF-FSDA). We also define two competitive baselines (1) Faster-FreeShot and (2) MT-FreeShot. Extensive experiments on the challenging M5-Malaria and Raabin-WBC datasets validate the effectiveness of MIAdapt. Without using any image from the source domain MIAdapt surpasses state-of-the-art source-free UDA (SF-UDA) methods by +21.3% mAP and few-shot domain adaptation (FSDA) approaches by +4.7% mAP on Raabin-WBC. Our code and models will be publicly available.
1 Introduction
Deep learning-based automatic microscopic image analysis plays a vital role in improving access to healthcare. However, these deep learning-based solutions are data-hungry, require high-quality, painstakingly annotated data, and are brittle. This challenge is worsened by differences in imaging protocols, devices and staining techniques across domains [18, 20]. As a result, models trained on a source domain often fail when applied to a new, unseen target domain. Unsupervised domain adaptation (UDA) methods have shown promising results in reducing domain shift through common approaches including feature alignment [1, 17], self-training [9, 10], image translation [27], and knowledge distillation [4].
Despite their effectiveness in standard settings, UDA methods depend heavily on large-scale unlabeled target data and labeled source-domain data. to learn domain-invariant features across domains. Most UDA methods struggle in scenarios where only a few target samples are available [23]. Furthermore, in most cases, the source data also remain inaccessible in the medical domain due to privacy constraints [2, 15]. To address these challenges, existing literature develops two parallel directions as: (1) Source-free unsupervised domain adaptation (SF-UDA) [14, 25, 7, 3] ensure source data privacy by enabling adaptation solely using a pre-trained source model (without direct access to source data) and sufficient target data. However, due to the absence of target labels, these methods suffer from low detection accuracy. (2) Few-shot domain adaptation (FSDA) methods [6, 8, 11] mitigates the scarcity of target domain data by employing cut-mix-based augmentation, leveraging sufficient labeled source data along with a limited number of labeled target samples. However, these methods require full source data access, limiting their use when unavailable.


Little to no attention has been paid to scenarios that address both, absence of source data and limited target data in object detection. Since obtaining labeled examples from the target domain is relatively easy and can significantly improve results, we propose MIAdapt—a Microscopic Imagery Adaptation method designed for source-free few-shot domain adaptation (SF-FSDA). MIAdapt operates without source data and relies on only a few labeled target-domain samples. To the best of our knowledge, this is the first work to explore SF-FSDA for multi-class medical imagery. While [21] address a similar problem in a simpler two-class setting outside the medical domain, the more complex multiclass scenario remains unexplored. Additionally, the absence of publicly available code limits reproducibility and further exploration of their approach. Our proposed method, MIAdapt, is a step towards enabling effective domain adaptation in challenging microscopic imaging tasks. Our main contributions are:
-
•
We propose a novel solution and strong baselines for less explored domain adaptation setting namely ‘SF-FSDA’ for Microscopic Imagery, removing the constraint of large source data availability during adaptation.
-
•
To address large domain gaps and class imbalance in few-shot images, a resolution-aware augmentation (RAug) is proposed.
-
•
A category-aware representation learning (CL) is designed to enhances intra-class similarity and inter-class discriminative features.
-
•
MIAdapt achieves comparable or better results against methods requiring source data or extensive targe data.
.
2 Methodology
2.1 Preliminaries
Let = be an annotated dataset from the source domain of size . where is an RGB image with = as corresponding class and bounding-box annotations of objects. Let =, be the set of target domain images, of size . is -shots dataset, and consisting of only -labeled images per class. We use samples picked by [8]. Let be the object detection model trained on source data and outputs Z detections , where denotes the class predictions and denotes the predicted bounding box for the proposal, respectively.
We assume that both source and target domains share the same label space . Unlike the generic FSDA and UDA methods where the source data is available, the proposed SF-FSDA setting only have access to source model and with .
2.2 Baselines for SF-FSDA Setting
As no baselines exist for source-free few-shot domain adaptation in object detection, we propose two competitive baselines by fine-tuning a source-trained model , using only a few labeled target images . Specifically, we introduce: (1) Faster-FreeShot: Leveraging Faster R-CNN [19] , we establish a fine-tuning baseline using Faster R-CNN [19] in the SF-FSDA setting. The is initialized with ImageNet [13] pretrained ResNet-50 backbone and then train it over the source data. Finally its adapted to few-shot target with task-specific loss.
(2) MT-FreeShot: Inspired by generalization of mean teacher frameworks [16, 22, 25], we introduce another baseline for the source-free few-shot setting. This approach enforces consistency between the student and teacher predictions, mitigating noisy updates to the student and reduce overfitting. The student () and teacher () networks are both initialized with and optimized using detection and consistency loss defined in the following section.

2.3 MIAdapt: SF-FSDA for Microscopic Imagery
Our proposed MIAdapt consists of two modules (1) Resolution-aware data Augmentation strategy (RAug) & (2) Category-aware representation Learning (CL).
Resolution-aware Data Augmentation (RAug): Medical samples are inherently imbalanced [18], with rare diseases co-occurring with common ones, further worsening class imbalance in few-shot settings. To address data imbalance, cut-mix strategies, e.g., CBCP by Inayat et al. [8], have been employed. Unfortunately, these approaches do not handle the differences of spatial resolution in-between images. As exhibited in microscopic benchmark M5 [20], the spatial resolution of images varies within the domain making these augmentation methods context agnostic (Fig. 3).
We propose RAug, a resolution-aware augmentation to incorporate a cell-size adjustment while preserving spatial resolution and aspect ratio between images. Following CBCP [8], we identify "rare images" given a class (ones having only a few samples of that class.) in k-shot target dataset . Let be the image with samples from class , let be the rare-image of class-. To ensure that pasted annotated cells are of same size as of other cells in , we leverage the relation between the spatial resolution of both and . Specifically, we select cell patch having resolution and place it in keeping the resolution intact if both images have the same spatial dimensions. If this condition is not satisfied, is resized to align with resolution while keeping its aspect ratio intact. Adjusted dimensions are:
| (1) |
These resized patches from containing cells of class are copy pasted to empty spaces (identified using ground-truth) in . Before pasting these patches go through two types of augmentation, random color intensity variation and gaussian blur. As a result, the cells are better augmented (Fig. 3 (b)) by balancing the class count, making the training process more effective (Tab. 4).
textbfMean Teacher Framework for SF-FSDA: Our mean teacher (MT) framework consists of two identical architectures termed student and teacher networks initialized with (source model). The target domain data is augmented using RAug strategy. Keeping image geometry intact, weak and strong augmentations [25] are applied to target image and fed to and as and respectively. The student network is trained by minimizing loss that includes classification and localization losses for the region proposal network (RPN), denoted as and , as well as for the region of interest (ROI) head, represented as and .
KL divergence-based is applied over between student and teacher logits, and to enhance consistency
Where student model is updated through gradient-based optimization, teacher is updated Exponential Moving Average (EMA) using .
| M5 (HCM1000x LCM1000x) | ||||||||||
| Method | gamet. | schiz. | troph. | ring | mAP50 | |||||
| Source [19] | 0.0 | 0.0 | 43.3 | 16.8 | 15.0 | |||||
| Shots | 2 | 5 | 2 | 5 | 2 | 5 | 2 | 5 | 2 | 5 |
| Faster-FreeShot | 37.0 | 30.0 | 11.5 | 12.6 | 59.7 | 52.0 | 35.5 | 32.3 | ||
| MT-FreeShot | 41.0 | 44.9 | 0.0 | 2.6 | 63.7 | 65.0 | 33.3 | 38.7 | ||
| MIAdapt(Ours) | 52.9 | 56.9 | 7.4 | 15.2 | 64.7 | 64.0 | 36.5 | 37.4 | ||
| Oracle [19] | 74.4 | 0.0 | 80.5 | 64.2 | 54.8 | |||||
| Raabin-WBC (M1 M2) | ||||||||||
| Method | l-lymph | neutro. | s-lymph. | mono. | mAP50 | |||||
| Source [19] | 30.4 | 40.5 | 71.9 | 56.8 | 49.9 | |||||
| Shots | 2 | 5 | 2 | 5 | 2 | 5 | 2 | 5 | 2 | 5 |
| Faster-FreeShot | 22.1 | 37.6 | 80.2 | 85.6 | 93.9 | 93.9 | 75.9 | 74.2 | ||
| MT-FreeShot | 16.9 | 30.7 | 61.8 | 70.7 | 90.7 | 91.7 | 73.2 | 72.7 | ||
| MIAdapt(Ours) | 22.3 | 51.2 | 75.8 | 81.6 | 93.3 | 93.6 | 73.0 | 75.7 | ||
| Oracle [19] | 93.0 | 92.9 | 96.4 | 81.4 | 90.9 | |||||
| Raabin-WBC (M1 M2) | ||||||||
| Method | arch. | target-imgs | l-lymph | neutro. | s-lymph. | mono. | mAP50 | |
| SF-UDA | IRG [25] | FR50 | 2033 | 11.3 | 53.4 | 92.3 | 60.0 | 54.2 |
| LODS [14] | FR101 | 2033 | 17.3 | 55.8 | 73.2 | 0.0 | 36.6 | |
| SF-YOLO [24] | yolov5 | 2033 | 37.1 | 82.8 | 21.0 | 9.7 | 37.7 | |
| SF-FSDA | MIAdapt(ours) | FR50 | 20 | 51.2 | 81.6 | 93.6 | 75.7 | 75.5 |
| M5 (HCM1000x LCM1000x) | ||||||||
| Method | arch. | target-imgs | gamet. | schiz. | troph. | ring | mAP50 | |
| SF-UDA | IRG [25] | FR50 | 837 | 0.0 | 0.0 | 70.7 | 33.8 | 26.1 |
| LODS [14] | FR101 | 837 | 0.0 | 0.0 | 3.9 | 16.2 | 5.0 | |
| SF-YOLO [24] | yolov5 | 837 | 36.3 | 0.0 | 26.4 | 16.8 | 19.9 | |
| SF-FSDA | MIAdapt(ours) | FR50 | 19 | 56.9 | 15.2 | 64.0 | 37.4 | 43.4 |
| Raabin-WBC (M1 M2) | |||||||||||||
| Method | arch. | src-imgs | l-lymph | neutro. | s-lymph. | mono. | mAP50 | ||||||
| Shots | 2 | 5 | 2 | 5 | 2 | 5 | 2 | 5 | 2 | 5 | |||
| FSDA | FsDet [26] | FR101 | 2052 | 41.5 | 38.1 | 17.5 | 44.1 | 23.7 | 29.6 | 23.1 | 8.7 | 26.5 | 30.1 |
| AsyFOD [5] | yolov5 | 2052 | 37.2 | 39.3 | 58.3 | 43.1 | 46.5 | 22.4 | 0.3 | 0.3 | 35.6 | 26.3 | |
| AcroFOD [6] | yolov5 | 2052 | 37.6 | 59.6 | 50.5 | 82.1 | 88.1 | 95.9 | 3.5 | 7.3 | 44.9 | 61.2 | |
| I2DA [8] | yolov5 | 2052 | 74.1 | 75.2 | 87.2 | 94.3 | 54.7 | 42.5 | 40.6 | 71.3 | 64.2 | 70.8 | |
| SF-FSDA | MIAdapt(ours) | FR50 | 0 | 22.3 | 51.2 | 75.8 | 81.6 | 93.3 | 93.6 | 73.0 | 75.7 | 66.1 | 75.5 |
| M5 (HCM1000x LCM1000x) | |||||||||||||
| Method | arch. | src-imgs | gamet. | schiz. | tropho. | ring | mAP50 | ||||||
| Shots | 2 | 5 | 2 | 5 | 2 | 5 | 2 | 5 | 2 | 5 | |||
| FSDA | FsDet [26] | FR101 | 837 | 11.8 | 12.3 | 0.0 | 0.0 | 27.7 | 30.7 | 5.4 | 8.6 | 11.2 | 12.9 |
| AsyFOD [5] | yolov5 | 837 | 14.9 | 36.8 | 1.2 | 2.8 | 59.4 | 64.7 | 28.7 | 30.9 | 26.0 | 33.5 | |
| AcroFOD [6] | yolov5 | 837 | 27.6 | 62.9 | 17.6 | 5.4 | 58.7 | 61.3 | 27.8 | 27.0 | 32.9 | 39.1 | |
| I2DA [8] | yolov5 | 837 | 71.4 | 68.2 | 11.4 | 30.4 | 66.9 | 65.6 | 29.3 | 31.5 | 44.7 | 48.9 | |
| SF-FSDA | MIAdapt(ours) | FR50 | 0 | 52.9 | 56.9 | 7.4 | 15.2 | 64.7 | 64.0 | 36.5 | 37.4 | 40.4 | 43.4 |
Category-aware representation Learning (CL): The foreground background similarity in microscopic images degrades RPN localization, leading to missed detections and false positives in cross-domain settings (see Fig. 4). Note that RPN is class-agnostic, and the feature extraction layer captures mostly class agnostic features. However, we have very few examples that are not sufficient to update the RPN in a standard way. Therefore, to guide the backbone features and enhance proposal quality, we further add similarity and dissimilarity loss. Encouraging that features for instances of class should be similar to each other but dissimilar to other classes, we hope that they will be different from the background. Note that in FaterRCNN, RPN also predicts the background class.
Specifically, we input to the the teacher network, and select the proposals with top objectness score. Using of IoU between proposals and the ground-truth bounding-boxes, we find associated class, for that proposal thus creating, set of bounding-box and class pairs . Proposals from the teacher network are extracted because they are more stable than the student network. However, these predicted proposals might be slightly erroneous or might miss the objects present in the image altogether, therefore we combine both and ground-truth to create . Using student network, , we compute feature-map from the backbone, when is presented. For each, respective features map from the and a global average pooling (GAP) is applied to create representation . In fig. 2 we illustrate the integration of class-aware feature alignment loss (CL) into our framework. The class-aware feature alignment loss comprises similarity loss and dissimilarity loss as defined in Eqs. 2 and 3,
| (2) |
where is the cosine similarity, and are the feature vector of and proposal for class . The loss in Eq. 2 enhances intra-class similarity; however, effective classification requires greater inter-class separability. We introduce a marginal dissimilarity loss (Eq. 3) to enforce separation between region proposals of different classes, where is the margin and . Due to the high computational cost, we only calculate dissimilarity between the mean feature vectors for each class across all region proposals.
| (3) |
The overall loss is defined as where and are the loss scaling hyper parameters.
3 Experiments
Datasets: M5 [20] is a large-scale malarial dataset containing images from high-cost (HCM) and low-cost (LCM) microscopes at three resolutions. We use 1000x images with the original splits for the source model. Raabin-WBC [12] is a white blood cell dataset collected using two microscopes. For both datasets, we follow 2-shot and 5-shot train splits as in [8].
Implementation Details: We follow the standard source-free setting as in [14, 25]. Number of teacher proposals, is set to 300 and teacher update rate . In all experiments, the student model is adapted for 10 epochs. To ensure consistency across datasets, loss parameters , , and (Eq. 3) are set to 1. Final results are reported using the last-epoch teacher model, with mAP@0.5 averaged over three runs using different random initial seeds.
3.1 Results and Analysis
SF-FSDA Comparisons: In Tab. 1 we compare the proposed MIAdapt against the baselines Faster-FreeShot and MT-FreeShot. On M5, MIAdapt outperforms baselines with a minimum margin of mAP +4.5% on 2-shot and +11.7% on 5-shot. We achieve notable mAP gains of +25.4% (2-shot) and +28.4% (5-shot) from source-Model. For less occurring classes, i.e., gamet. & schiz. MIAdapt achieves a gain of +56.9% and +15.2%, respectively.
On Raabin-WBC, MIAdapt also achieves prominent gain of +16.2% on 2-shot and +25.6% on 5-shot from source trained model.
Compared to baselines, the MIAdapt is more stable with minimal standard deviation on both M5 and Raabin-WBC datasets as shown in Tab. 1.
| Method | MT-FreeShot (baseline) | MIAdapt w/CBCP [8] | MIAdapt w/RAug (Ours) |
| mAP50 | 37.8 | 41.3 | 43.4 |

Comparison with SF-UDA: Tab. 2 shows the comparisons of MIAdapt with the SF-UDA methods. MIAdapt outperforms the SF-UDA methods with a minimum margin of +21.3% on Raabin-WBC and +17.3% on M5-Malaria dataset. Notably, SF-UDA methods fail to adapt to less-frequent Shizont category resulting 0.0% mAP. This shows the less effectiveness of the SF-UDA methods in handling large domain gaps and class imbalance in microscopic imagery.
Comparison with FSDA: Tab. 3 presents a comparison of MIAdapt with FSDA methods. On M5, witout having access to source domain images, MIAdapt achieves mAP of 40.4% (2-shot) and 43.4% (5-shot), significantly outperforming [26, 5, 6]. The closest competitor, I2DA [8], achieves 44.7% and 48.9% mAP using 837 source domain images alongside target images. On Raabin-WBC, MIAdapt outperforms all FSDA methods with a minimum margin of +1.9% mAP on 2-shot and +4.7% mAP on 5-shot.
Ablation: To analyze the effectiveness of the proposed RAug in MIAdapt, we perform M5 adaptation comparison using [8]. As shown in Tab. 4, we empirically find that RAug achieves a +5.6% mAP improvement over the baseline and +2.1% compared to [8].
Qualitative Results: Fig. 5 shows MIAdapt outperforms the source model and baseline. It improves malarial stage detection on M5 and reduces class confusion on Raabin-WBC, enhancing Neutrophil and Large-Lymph detection.
4 Conclusion
We propose a novel solution for SF-FSDA setting in microscopic object detection, leveraging only a pre-trained source model and a few labeled target samples. To address domain discrepancies, we incorporate a resolution-aware augmentation strategy to mitigate class imbalance and a class-aware feature alignment method to align the instance-level features. In addition, we design competitive baselines including one using mean-teacher framework. Extensive experiments show that MIAdapt achieves comparable or better performance to state-of-the-art FSDA and SF-UDA methods.
References
- [1] Chaoqi Chen, Jiongcheng Li, Zebiao Zheng, Yue Huang, Xinghao Ding, and Yizhou Yu. Dual bipartite graph learning: A general approach for domain adaptive object detection. In Proceedings of the IEEE/CVF International Conference on Computer Vision, pages 2703–2712, 2021.
- [2] Cheng Chen, Quande Liu, Yueming Jin, Qi Dou, and Pheng-Ann Heng. Source-free domain adaptive fundus image segmentation with denoised pseudo-labeling. In Medical Image Computing and Computer Assisted Intervention–MICCAI 2021: 24th International Conference, Strasbourg, France, September 27–October 1, 2021, Proceedings, Part V 24, pages 225–235. Springer, 2021.
- [3] Qiaosong Chu, Shuyan Li, Guangyi Chen, Kai Li, and Xiu Li. Adversarial alignment for source free object detection. In Proceedings of the AAAI Conference on Artificial Intelligence, volume 37, pages 452–460, 2023.
- [4] Jinhong Deng, Wen Li, Yuhua Chen, and Lixin Duan. Unbiased mean teacher for cross-domain object detection. In Proceedings of the IEEE/CVF Conference on Computer Vision and Pattern Recognition, pages 4091–4101, 2021.
- [5] Yipeng Gao, Kun-Yu Lin, Junkai Yan, Yaowei Wang, and Wei-Shi Zheng. Asyfod: An asymmetric adaptation paradigm for few-shot domain adaptive object detection. In Proceedings of the IEEE/CVF Conference on Computer Vision and Pattern Recognition, pages 3261–3271, 2023.
- [6] Yipeng Gao, Lingxiao Yang, Yunmu Huang, Song Xie, Shiyong Li, and Wei-Shi Zheng. Acrofod: An adaptive method for cross-domain few-shot object detection. In European Conference on Computer Vision, pages 673–690. Springer, 2022.
- [7] Yan Hao, Florent Forest, and Olga Fink. Simplifying source-free domain adaptation for object detection: Effective self-training strategies and performance insights. In European Conference on Computer Vision, pages 196–213. Springer, 2024.
- [8] Sumayya Inayat, Nimra Dilawar, Waqas Sultani, and Mohsen Ali. Few-shot domain adaptive object detection for microscopic images. In International Conference on Medical Image Computing and Computer-Assisted Intervention, pages 98–108. Springer, 2024.
- [9] Javed Iqbal and Mohsen Ali. In Proceedings of the IEEE/CVF Winter Conference on Applications of Computer Vision, pages 1864–1873, 2020.
- [10] Javed Iqbal, Rehan Hafiz, and Mohsen Ali. Fogadapt: Self-supervised domain adaptation for semantic segmentation of foggy images. Neurocomputing, 501:844–856, 2022.
- [11] Matthew R Keaton, Ram J Zaveri, and Gianfranco Doretto. Celltranspose: Few-shot domain adaptation for cellular instance segmentation. In Proceedings of the IEEE/CVF Winter Conference on Applications of Computer Vision, pages 455–466, 2023.
- [12] Zahra Mousavi Kouzehkanan, Sepehr Saghari, Sajad Tavakoli, Peyman Rostami, Mohammadjavad Abaszadeh, Farzaneh Mirzadeh, Esmaeil Shahabi Satlsar, Maryam Gheidishahran, Fatemeh Gorgi, Saeed Mohammadi, et al. A large dataset of white blood cells containing cell locations and types, along with segmented nuclei and cytoplasm. Scientific reports, 12(1):1123, 2022.
- [13] Alex Krizhevsky, Ilya Sutskever, and Geoffrey E Hinton. Imagenet classification with deep convolutional neural networks. Advances in neural information processing systems, 25, 2012.
- [14] Shuaifeng Li, Mao Ye, Xiatian Zhu, Lihua Zhou, and Lin Xiong. Source-free object detection by learning to overlook domain style. In Proceedings of the IEEE/CVF Conference on Computer Vision and Pattern Recognition, pages 8014–8023, 2022.
- [15] Xiaofeng Liu, Fangxu Xing, Chao Yang, Georges El Fakhri, and Jonghye Woo. Adapting off-the-shelf source segmenter for target medical image segmentation. In Medical Image Computing and Computer Assisted Intervention–MICCAI 2021: 24th International Conference, Strasbourg, France, September 27–October 1, 2021, Proceedings, Part II 24, pages 549–559. Springer, 2021.
- [16] Yen-Cheng Liu, Chih-Yao Ma, Zijian He, Chia-Wen Kuo, Kan Chen, Peizhao Zhang, Bichen Wu, Zsolt Kira, and Peter Vajda. Unbiased teacher for semi-supervised object detection. arXiv preprint arXiv:2102.09480, 2021.
- [17] Muhammad Akhtar Munir, Muhammad Haris Khan, M Sarfraz, and Mohsen Ali. Ssal: Synergizing between self-training and adversarial learning for domain adaptive object detection. Advances in Neural Information Processing Systems, 34, 2021.
- [18] Abdul Rehman, Talha Meraj, Aiman Mahmood Minhas, Ayisha Imran, Mohsen Ali, and Waqas Sultani. A large-scale multi domain leukemia dataset for the white blood cells detection with morphological attributes for explainability. In International Conference on Medical Image Computing and Computer-Assisted Intervention, pages 553–563. Springer, 2024.
- [19] Shaoqing Ren, Kaiming He, Ross Girshick, and Jian Sun. Faster r-cnn: Towards real-time object detection with region proposal networks. IEEE transactions on pattern analysis and machine intelligence, 39(6):1137–1149, 2016.
- [20] Waqas Sultani, Wajahat Nawaz, Syed Javed, Muhammad Sohail Danish, Asma Saadia, and Mohsen Ali. Towards low-cost and efficient malaria detection. In 2022 IEEE/CVF Conference on Computer Vision and Pattern Recognition (CVPR), pages 20655–20664. IEEE, 2022.
- [21] Han Sun, Rui Gong, Konrad Schindler, and Luc Van Gool. Sf-fsda: Source-free few-shot domain adaptive object detection with efficient labeled data factory. arXiv preprint arXiv:2306.04385, 2023.
- [22] Antti Tarvainen and Harri Valpola. Mean teachers are better role models: Weight-averaged consistency targets improve semi-supervised deep learning results. Advances in neural information processing systems, 30, 2017.
- [23] Eric Tzeng, Judy Hoffman, Kate Saenko, and Trevor Darrell. Adversarial discriminative domain adaptation. In Proceedings of the IEEE conference on computer vision and pattern recognition, pages 7167–7176, 2017.
- [24] Simon Varailhon, Masih Aminbeidokhti, Marco Pedersoli, and Eric Granger. Source-free domain adaptation for yolo object detection. arXiv preprint arXiv:2409.16538, 2024.
- [25] Vibashan VS, Poojan Oza, and Vishal M Patel. Instance relation graph guided source-free domain adaptive object detection. In Proceedings of the IEEE/CVF Conference on Computer Vision and Pattern Recognition, pages 3520–3530, 2023.
- [26] Xin Wang, Thomas E Huang, Trevor Darrell, Joseph E Gonzalez, and Fisher Yu. Frustratingly simple few-shot object detection. arXiv preprint arXiv:2003.06957, 2020.
- [27] Jun-Yan Zhu, Taesung Park, Phillip Isola, and Alexei A Efros. Unpaired image-to-image translation using cycle-consistent adversarial networks. In Proceedings of the IEEE international conference on computer vision, pages 2223–2232, 2017.